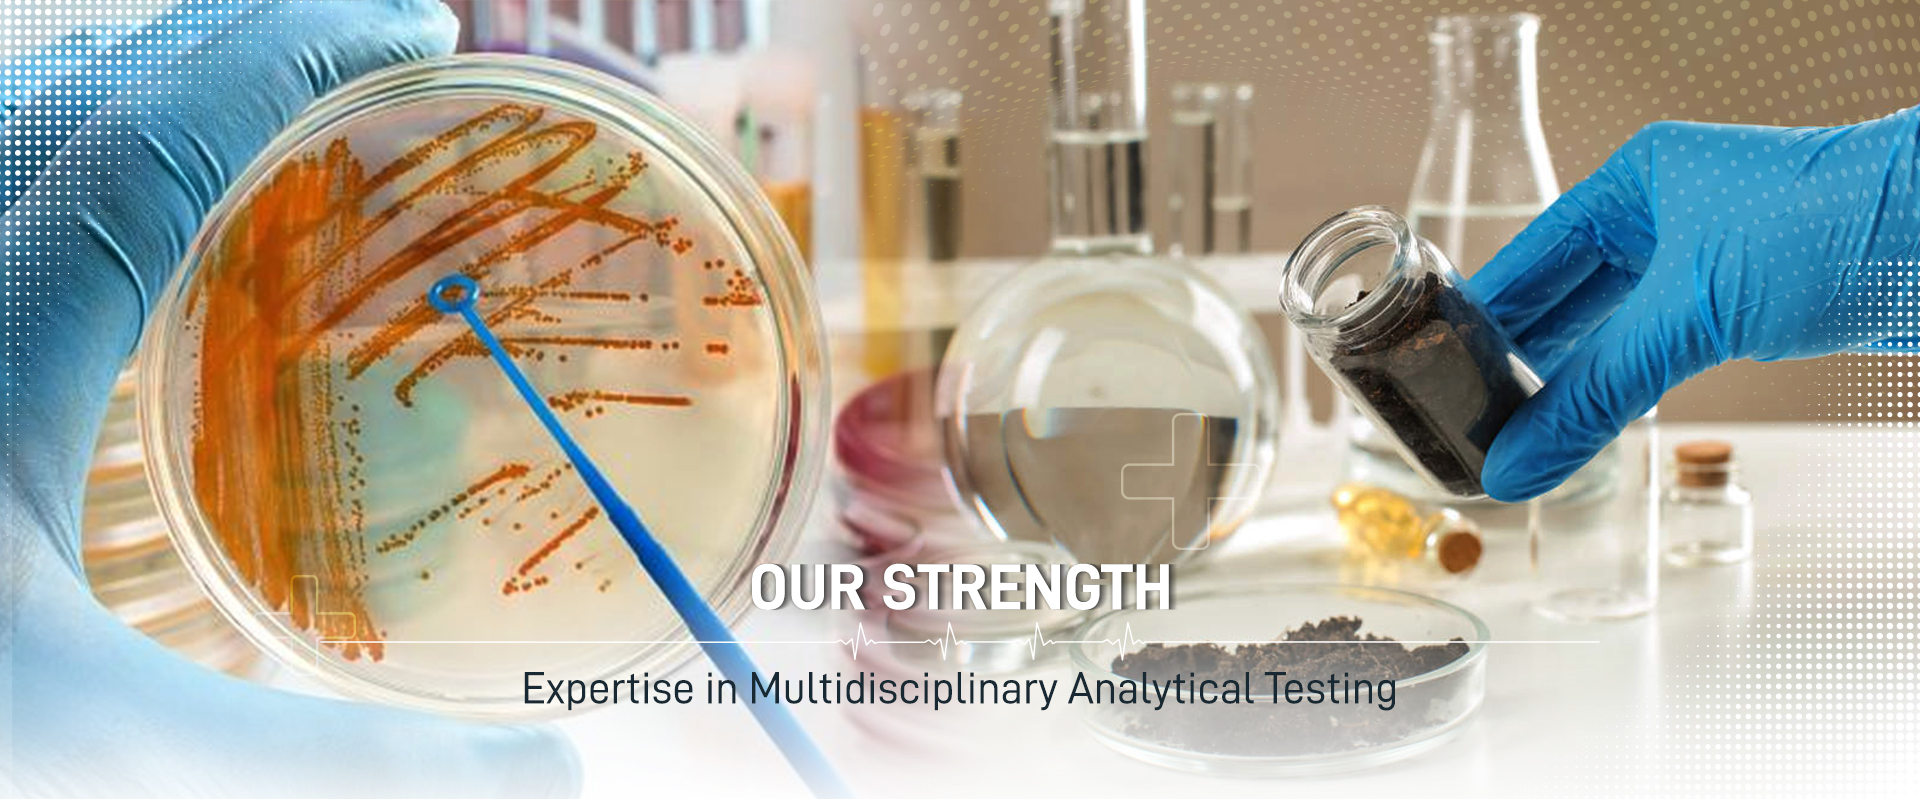
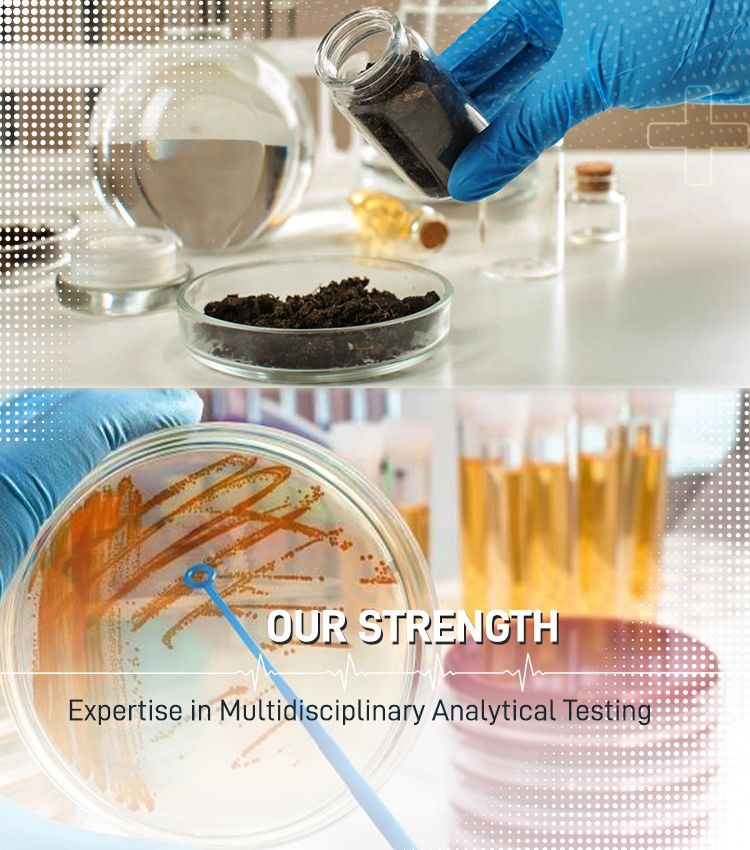

Welcome to
TATTVA ANALYTICAL LABORATORIES
Tattva Analytical Laboratories is a premier NABL accredited, MOEF recognised and ISO 45001 certified analytical laboratory in field of Food, Water and Environment testing.
Our systematic process and ease of operation with latest techology have enabled us to grow with the trends in delivering the required services. Of course, all these has been possible mainly due to our customer's support which we are sure will grow more and more in the days to come.
ABOUT US


HIGH QUALITY LAB SERVICES
We have a team of exceptionally skilled staff with vast experience in the relevant fields, ready to serve you at their best.
Client describes requirements
Lab Generate Proposal
Testing Begins
Reports Delivered
OUR SERVICES
Quality is our prime focus and we stand fully committed to the quality of our products and service.
Sector's We Serve
TESTIMONIALS
What Clients Say
WE ARE HERE FOR YOU
MAKE AN APPOINTMENT TODAY
PLEASE FILL A FORM
LET'S TALK ABOUT IT
We are here for You..